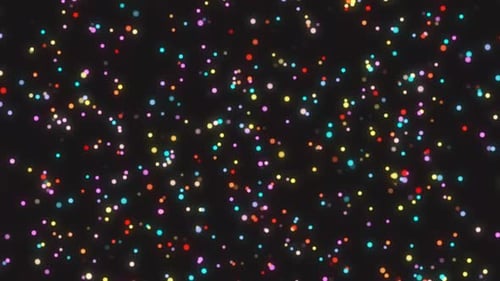
Colorful Glowing Particles Celebration Background Animation

Royalty-Free 2K Brighten Skin Backgrounds Motion Graphics
Browse 2K brighten skin Backgrounds Motion Graphics templates in our library. If you don't find one at first glance, try using the filters!
How satisfied are you with your Stock Video experience today?